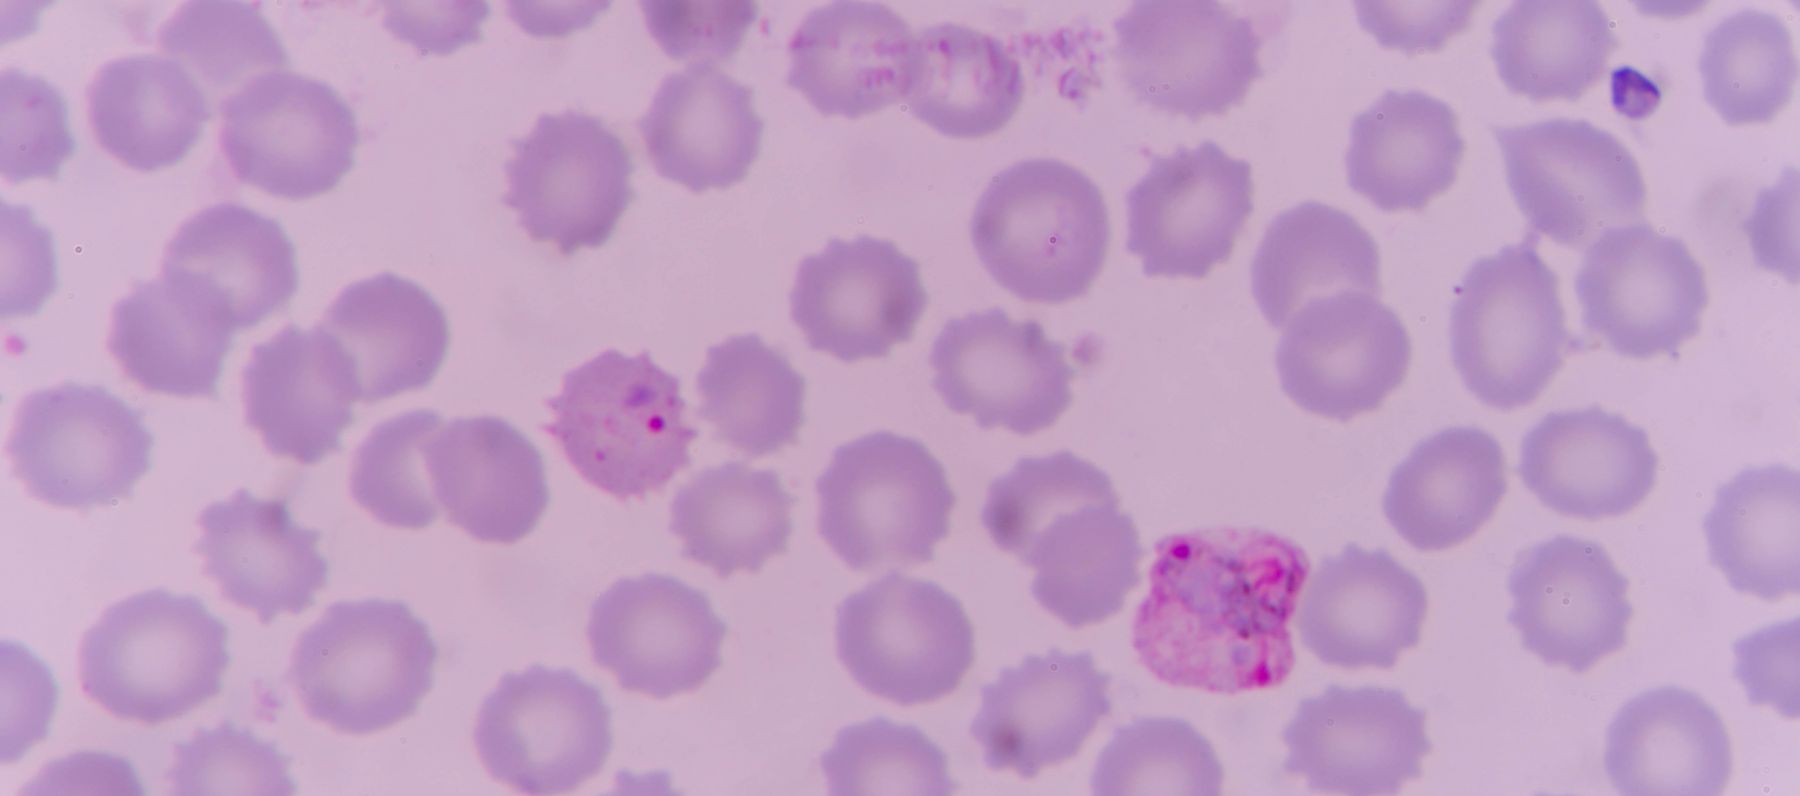
Malaria testing in Guyana

Sign up for our CIPI newsletter
Improving testing for Malaria in Guyana
While malaria remains endemic in the country, Guyana has made significant gains in the fight against the disease.
But despite this progress, 93% of all new cases of Malaria are found in just four of the country’s regions: 1, 7, 8, and, to a lesser extent, region 9.
What these regions have in common is a high concentration of mining, logging and Amerindian communities in remote areas of the Guyanese hinterlands.

THE CHALLENGE
In order to increase access to malaria testing and treatment services in the most affected regions, the Guyanese Ministry of Public Health (MoPH), Pan American Health Organization (PAHO), and Global Fund to Fight AIDS, Tuberculosis and Malaria (GFATM) are working together to introduce rapid diagnostic tests (RDTs) and treatment for malaria into mining camps and the surrounding communities.
OUR RESPONSE
As part of the USAID-funded Breakthrough ACTION consortium, ThinkPlace was engaged to lead a human-centred approach to deeply understanding the motivations and behaviours of these communities, and to ultimately develop interventions that improve access to malaria services that can be implemented at scale.
A collaborative Breakthrough ACTION design team consisting of ThinkPlace designers, practitioners from Johns Hopkins University Centre for Communication Programs (JHU CCP), local MoPH officers and regional Vector Control officers conducted a total of 108 interviews across 14 locations in two endemic regions of Guyana.
HOW WE DID IT
From the initial discovery phase, eleven insights were identified that would inform the development of multiple intervention ideas and prototypes. It was found that the malaria parasite was deeply misunderstood for a variety of reasons, and this had a significant effect on care seeking and treatment adherence behaviours.
Through several days of intense co-design workshops, the design team worked with representatives from a range of local organisations to generate 792 raw ideas and refine these into eight emergent concepts to be prototyped.
An iterative ‘Design and Test’ process allowed the design team to develop and sharpen these concepts based on feedback from the communities visited during the discovery phase. Ultimately five interventions were recommended to the MoPH, ranging from comprehensive and targeted communication campaigns, to job aids for volunteer testers, to product-based adherence initiatives.

THE IMPACT
ThinkPlace has assisted in the rollout of high-fidelity pilots of these interventions in specific communities throughout Regions 7 and 8.
Based on the deep learnings from the discovery phase, the interventions currently being piloted cut across all stages of a community member’s experience with malaria and interacting with the health system: from building awareness the need for testing and treatment, to improving access to services, to becoming advocates and spreading accurate information to their peers.






